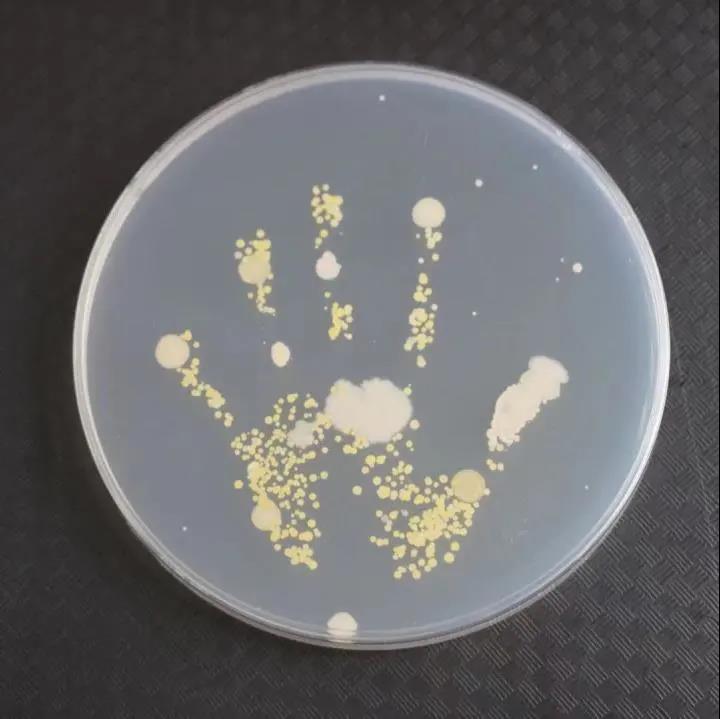

你正確洗手了嗎? 重視這個簡單但重要的動作!
2021年10月18日15:13 |
10月15日是全球洗手日。擁有一雙干凈的手,對我們的健康非常重要。
“哇,我的手上有那么多細菌!”10月15日,楊浦區市東幼兒園的蔣沁芝小朋友收到了楊浦區疾病預防控制中心發送給她的一張圖片。這是從她剛做完游戲的小手上采集的細菌,經過48小時的培養,這些細菌又“長”成了一只小手的形狀。
近日,一場以“小習慣、大健康”為主題的全球洗手日活動在楊浦區市東幼兒園舉行。疾病的傳播過程中,雙手扮演著重要的角色。手是最常接觸物體的部位,非常容易沾染大量病菌。世界衛生組織將每年的10月15日確定為 “全球洗手日”,呼吁全世界重視“洗手”這個簡單但重要的動作,提醒公眾養成勤洗手的好習慣。

洗手能有效降低腸道傳染病和呼吸道傳染病的發生和傳播。做好幼兒的手衛生科普教育,可以幫助幼兒從小養成健康的生活方式,對其一生的健康都有重要的意義。為此,區疾控工作人員精心設計了一系列生動的小游戲,如射擊、擲骰子、跳房子等。
小朋友們在老師和楊浦區疾病預防控制中心工作人員的帶領下一起做游戲,學唱洗手歌。蔣沁芝小朋友說:“我回去之后要把洗手歌唱給爸爸媽媽聽,讓他們跟著我一起洗手!
在玩了這么多的游戲后,工作人員讓小朋友將活動后臟臟的小手和正確洗干凈后的小手分別在培養皿中按壓出一個掌印,再把它們送到疾控實驗室,并在37攝氏度下進行48小時的培養。目前小朋友們都收到了來自實驗室的反饋圖片。
洗手前

洗手后
“正確洗手是最價廉、最有效的健康干預方式!睏钇謪^疾病預防控制中心副主任何露表示。后續,小朋友們將在家長的幫助下通過閱讀繪本、觀看視頻、每天洗手打卡等活動,逐步養成良好的個人衛生習慣。

市民朋友們,一定要記得及時洗手哦。
(來源:上海楊浦)
(責編:沐一帆、軒召強)
分享讓更多人看到
相關新聞
- 評論
- 關注
























第一時間為您推送權威資訊
報道全球 傳播中國
關注人民網,傳播正能量